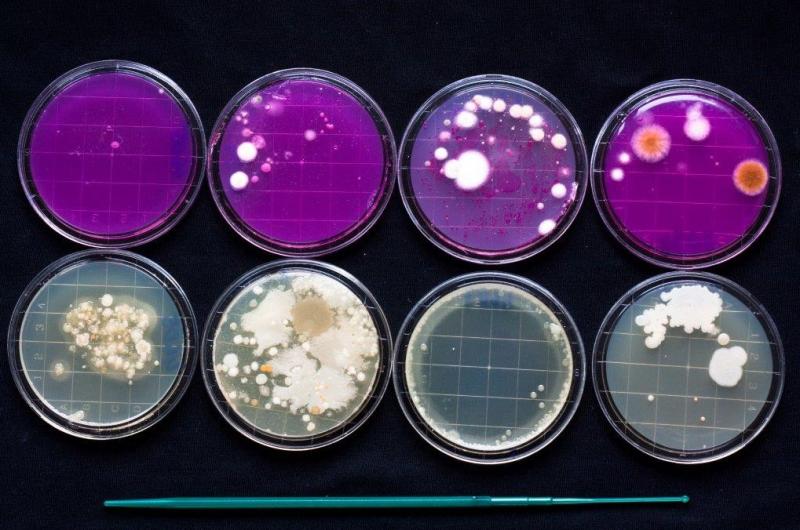

Vzorkování a laboratorní rozbory pitných vod a užitkových vod
Orlická Laboratoř, s.r.o. Česká Třebová, Ústí nad Orlicí, Žamberk se zabývá odběry, analýzami a rozbory včetně rozborů pitných a užitkových vod. Laboratoř je akreditována Českým institutem pro akreditaci, o.p.s. dle ČSN EN ISO/IEC 17025, registrovaná pod č. 1277. Odběry, analýzy, rozbory Voda z…